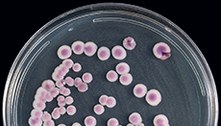
Hospital em PE tem surto de fungo multirresistente, informa Anvisa

Brasil registra 133 mortes e 87.471 novos casos em 24h

Filippo Venezia/EFE/EPA – 23.12.2021
Nesta quarta-feira (12), o Brasil registrou 133 mortes e 87.471 novos casos diagnosticados de Covid-19, de acordo com os dados enviados pelos estados ao Ministério da Saúde e ao Conass (Conselho Nacional de Secretários de Saúde). A média móvel de óbitos nos últimos sete dias é de 123, e a média móvel de novos casos é de 52.261.
O país contabiliza 620.371 mortes e 22.716.931 pessoas que já foram diagnosticadas com a doença. São Paulo, Rio de Janeiro, Paraná e Minas Gerais são os estados com o maior número de óbitos, respectivamente.
De acordo com o Ministério da Saúde, mais de 21 milhões de pessoas já se recuperaram da Covid-19 no país.
Veja também
-
Saúde
Hospital em PE tem surto de fungo multirresistente, informa Anvisa
-
Saúde
Diretor da OMS: ‘Não é momento de dizer que é um vírus bem-vindo’
-
Saúde
Covid pode passar despercebida em meio a surto de gripe e resfriado
Segundo o Conass, a taxa de letalidade do coronavírus no Brasil é de 2,8% e a taxa de mortalidade para cada 100 mil habitantes é de 295,2.
O Vacinômetro do R7 mostra que, no Brasil, a primeira dose da vacina contra a Covid-19 já foi aplicada em mais de 161,8 milhões de pessoas, o que corresponde a 75,8% da população, sendo que mais de 144,9 milhões já receberam a segunda dose ou uma vacina de dose única. O número de imunizados com a dose de reforço é de 31,3 milhões, equivalente a 14,6% da população.
Acompanhe o Vacinômetro em tempo real:
Fonte: Saúde R7